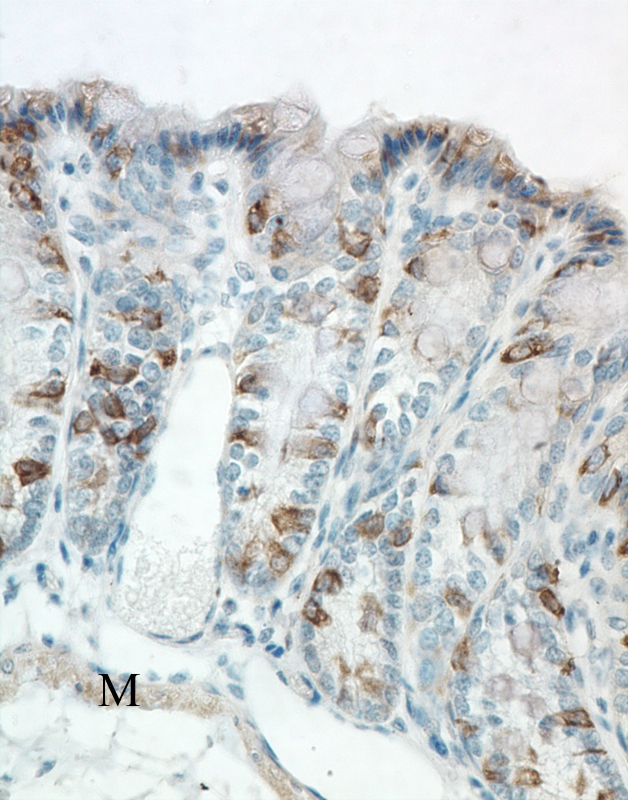

Pathology Image Detail
Caption |
Colon - Normal tissue. Individual epithelial cells of colonic glands are strongly labeled for alpha-catenin. Smooth muscle fibers of the muscularis mucosa show moderate diffuse cytoplasmic labeling for alpha-catenin. |
Description |
Large intestine, colon -Normal tissue. |
Age at Necropsy |
unknown |
Contributor |
Mikaelian I (J:94310) |
Pathologist |
Mikaelian I (J:94310) |
Method |
IHC for alpha catenin |
Type: antibody |
|
Model |
|
Strain |
|